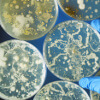
Weighing Equipment in Microbiology

25,Feb, 2020
Adam Equipment to Present Lab Balances a...
Adam Equipment, will highlight several of its lab balances, scales and accessories at Pittcon from March 3 to 5. Adam pe...
25,Feb, 2020
Using Density Kits with Balances
This guide shows you how to use the Adam Equipment density kits to figure out the density of an object using an Adam lab...
24,Feb, 2020
Weighing Equipment in Microbiology
The microbiology field has seen considerable growth and its knowledge is used in various industries, from environmental ...
12,Feb, 2020
Balances in Materials Testing for Constr...
In nearly any industry, the quality of the materials used can often mean the difference between success and failure. Thi...